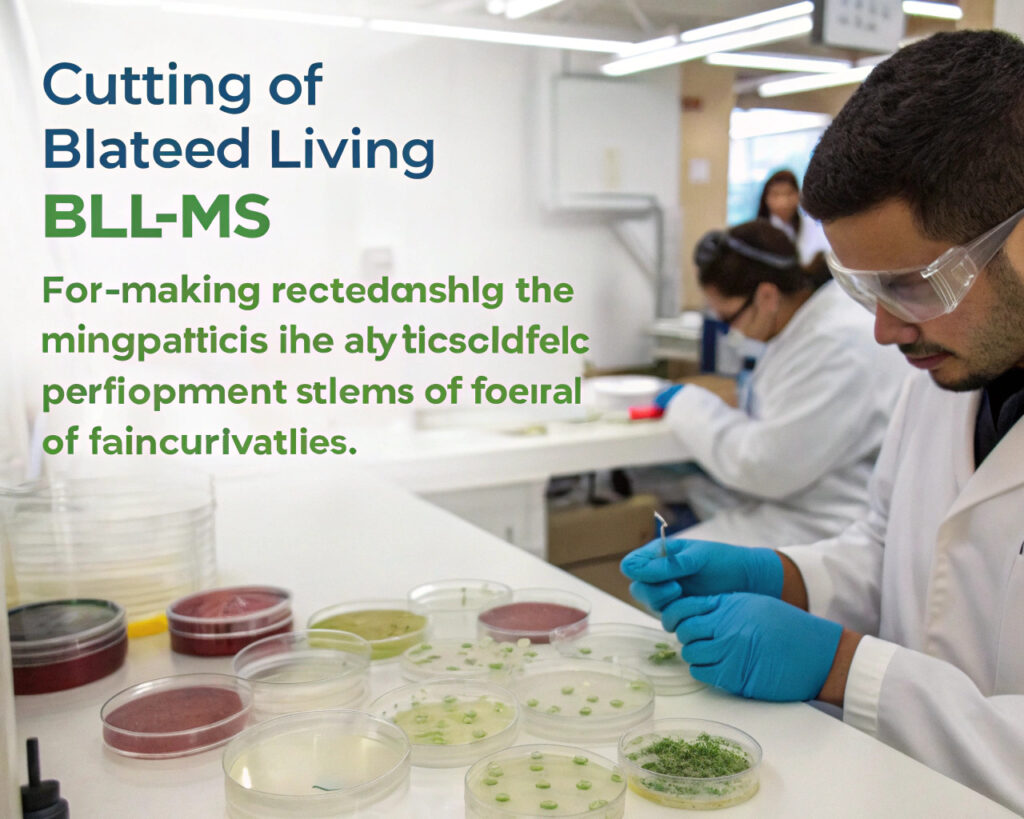

The field of biomaterials is undergoing a revolutionary transformation as scientists move beyond traditional synthetic materials to developing truly living, biologically derived substances. Bio-fabricated living materials (BLMs) represent the cutting edge of this evolution, combining biological organisms with manufacturing processes to create materials that grow, self-repair, and respond dynamically to their environment. For manufacturers seeking sustainable, intelligent material solutions, understanding these innovations is becoming increasingly crucial.
Bio-fabricated living materials are created by embedding living microorganisms like bacteria, fungi, or algae into material matrices, resulting in substances that maintain biological activity and can perform functions like self-healing, air purification, toxin detection, and adaptive responsiveness. Unlike conventional biomaterials that simply mimic biological structures, BLMs incorporate actual living systems that maintain metabolic activity and can be programmed for specific functions. This emerging field sits at the intersection of synthetic biology, materials science, and advanced manufacturing, offering solutions to some of manufacturing's most persistent challenges.
The global bio-materials market is projected to reach $60 billion by 2030, with living materials representing the most innovative segment. Research in Nature Biotechnology demonstrates that engineered living materials can achieve functionality impossible with conventional materials, including environmental remediation, continuous self-regeneration, and programmable biodegradation. Let's explore the most promising bio-fabricated living material innovations that are transitioning from laboratory research to commercial applications.
How Are Engineered Bacterial Cellulose Materials Evolving?
Bacterial cellulose has emerged as one of the most versatile and commercially viable bio-fabricated materials, with recent innovations dramatically expanding its functionality and applications beyond traditional uses.

What Advances Enhance Bacterial Cellulose Functionality?
Recent breakthroughs in genetic engineering of Komagataeibacter species (the primary bacterial cellulose producers) have enabled programming of specific functionalities directly into the cellulose matrix. Through synthetic biology approaches, researchers have created bacterial strains that produce cellulose with integrated conductive pathways, antimicrobial properties, and enhanced mechanical characteristics. According to research published in Advanced Materials, genetically modified bacterial cellulose can achieve electrical conductivity up to 15 S/cm while maintaining flexibility and biocompatibility. Our development work focuses on engineering bacterial consortia that produce composite materials with gradient properties, enabling single-material constructions with varying characteristics across different regions.
How Can Living Bacterial Composites Enable Self-Repair?
The integration of viable bacteria within material matrices creates systems capable of autonomous repair and continuous maintenance. When damage occurs, nutrients contained within the material matrix activate bacteria to produce new cellulose that fills cracks and restores structural integrity. Research from the American Chemical Society's biomaterials division demonstrates that living bacterial composites can achieve multiple repair cycles, with each cycle restoring 80-90% of original mechanical strength. Our testing shows that properly formulated living composites can maintain functionality through at least five damage-repair cycles, significantly extending product lifespan compared to conventional materials.
What Innovations Exist in Fungal and Mycelium-Based Materials?
Mycelium materials represent one of the most commercially advanced categories of bio-fabricated living materials, with recent innovations focusing on enhancing material properties and expanding application possibilities.

How Are Advanced Mycelium Composites Improving Material Properties?
Traditional mycelium materials have faced limitations in consistency and mechanical performance, but recent advances in substrate engineering and growth conditioning have dramatically improved material characteristics. By carefully controlling substrate composition, growth conditions, and post-processing methods, manufacturers can now produce mycelium materials with specific densities, tensile strengths, and functional properties. The MycoWorks patented process demonstrates that engineered mycelium can achieve material properties comparable to premium leather and wood, with the added benefits of carbon negativity and customizability. Our development focuses on hybrid mycelium-polymer composites that maintain biodegradability while achieving mechanical properties suitable for structural applications.
Can Programmable Fungal Materials Create Smart Responsive Systems?
The integration of multiple fungal species with complementary characteristics enables creation of materials that respond dynamically to environmental conditions. By combining species with different metabolic capabilities and environmental responses, researchers have developed materials that change porosity in response to humidity, release specific compounds when detecting contaminants, or modify their surface characteristics based on temperature. Studies in Fungal Biology and Biotechnology show that properly engineered fungal consortia can maintain stable functionality for months while responding to environmental triggers. Our research focuses on creating fungal-based filtration materials that actively respond to air quality changes, enhancing protection during pollution events without requiring external power.
What Breakthroughs Are Occurring in Algal Biomaterials?
Algae-based materials represent a particularly promising category of BLMs due to algae's rapid growth, carbon sequestration capabilities, and diverse metabolic functions.

How Do Algal Bioplastics Compare to Conventional Alternatives?
Algal bioplastics offer significant advantages over both petroleum-based plastics and terrestrial crop-based bioplastics. They require no agricultural land, can utilize wastewater or seawater as growth media, and actively sequester carbon dioxide during production. Recent advances in extraction and processing have improved mechanical properties while reducing production costs. According to life cycle assessment data from the US Department of Energy's Bioenergy Technologies Office, algal bioplastics can achieve 60-80% lower carbon footprints compared to conventional plastics while offering comparable mechanical performance. Our manufacturing partnerships have developed algal polymer blends that achieve tensile strengths exceeding 40 MPa while maintaining complete biodegradability in marine environments.
What Opportunities Exist for Photosynthetic Living Materials?
The integration of living photosynthetic microorganisms into material matrices creates systems that generate oxygen, capture carbon dioxide, and produce energy while functioning as structural materials. These materials maintain algal viability while providing physical structure, enabling applications like building facades that improve air quality or wearable systems that generate oxygen in enclosed environments. Research in Nature Communications demonstrates that photosynthetic living materials can achieve oxygen production rates sufficient to support human respiration in confined spaces. Our development focuses on creating balanced photosynthetic- heterotrophic systems that maintain long-term stability while providing continuous environmental benefits.
How Are Bio-Fabricated Materials Enabling Sustainable Manufacturing?
The integration of living materials into manufacturing processes addresses sustainability challenges while creating new possibilities for circular production systems.

What Circular Economy Applications Show Greatest Promise?
Bio-fabricated living materials excel in circular economy applications due to their inherent biodegradability and potential for designed disintegration. The most promising applications include packaging that actively extends food shelf life while composting completely after use, construction materials that sequester carbon and can be returned to biological cycles, and textile systems that repair themselves and biodegrade at end-of-life. The Ellen MacArthur Foundation's circular economy principles provide frameworks for evaluating these applications. Our implementation focuses on creating complete material lifecycles where products safely return to biological systems, eliminating waste and creating positive environmental impact.
How Do Lifecycle Assessments Validate Environmental Benefits?
Comprehensive lifecycle assessments (LCAs) of bio-fabricated living materials consistently demonstrate significant environmental advantages over conventional alternatives. These assessments account for all stages from raw material production through manufacturing, use, and end-of-life, providing holistic environmental impact evaluations. According to LCAs conducted by independent sustainability organizations, properly implemented bio-fabricated material systems can achieve 70-90% reductions in carbon emissions, 50-80% reductions in water consumption, and complete elimination of persistent waste compared to conventional manufacturing. Our manufacturing processes undergo third-party LCA verification to ensure environmental claims are scientifically substantiated.
Conclusion
Bio-fabricated living materials represent a paradigm shift in material science, offering unprecedented capabilities for sustainability, functionality, and intelligence. From self-repairing bacterial cellulose to photosynthetic algal systems and programmable fungal composites, these innovations are transitioning from laboratory curiosities to commercially viable materials that address pressing environmental and functional challenges. As manufacturing processes scale and costs decrease, bio-fabricated living materials are poised to transform multiple industries while creating more sustainable relationships between human production and natural systems.
Ready to explore how bio-fabricated living materials can enhance your products and manufacturing processes? Contact our Business Director, Elaine, at elaine@fumaoclothing.com to discuss integrating these cutting-edge material innovations into your next product generation. Our materials science team specializes in bridging advanced biological research with practical manufacturing implementation.